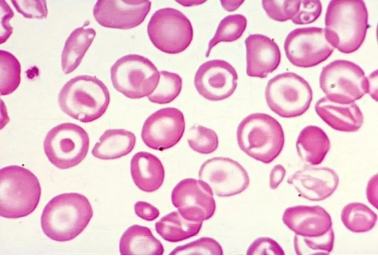

Αυτή η ενότητα εισάγει τους μαθητές στη θαλασσαιμία, μια διαταραχή του αίματος που προκαλείται από μεταλλάξεις στο γονίδιο HBB, οι οποίες εμποδίζουν την παραγωγή φυσιολογικής αιμοσφαιρίνης. Οι μαθητές θα ανακαλύψουν πρώτα τι είναι η θαλασσαιμία και πώς επηρεάζει το σώμα. Στη συνέχεια, θα εξερευνήσουν πώς η γονιδιακή θεραπεία — χρησιμοποιώντας εργαλεία όπως το CRISPR-Cas9 — μπορεί να επιδιορθώσει ή να αντικαταστήσει το ελαττωματικό DNA, προσφέροντας τη δυνατότητα ίασης.
Η ενότητα ακολουθεί τη μεθοδολογία Εξερεύνηση – Εκτέλεση – Ενίσχυση:
- Εξερεύνηση: Δημιουργία μιας βάσης γνώσεων για τη θαλασσαιμία και τη γονιδιακή θεραπεία.
- Εκτέλεση: Χρήση προσομοιώσεων Επαυξημένης Πραγματικότητας και πρακτικών ασκήσεων για την εξάσκηση στη “διόρθωση” ελαττωματικών γονιδίων.
- Ενίσχυση: Στοχασμός πάνω σε προχωρημένες εφαρμογές, ηθικές συζητήσεις και το μέλλον των γενετικών θεραπειών.
Δημιουργήθηκε από τους Εταίρους του CEIPES